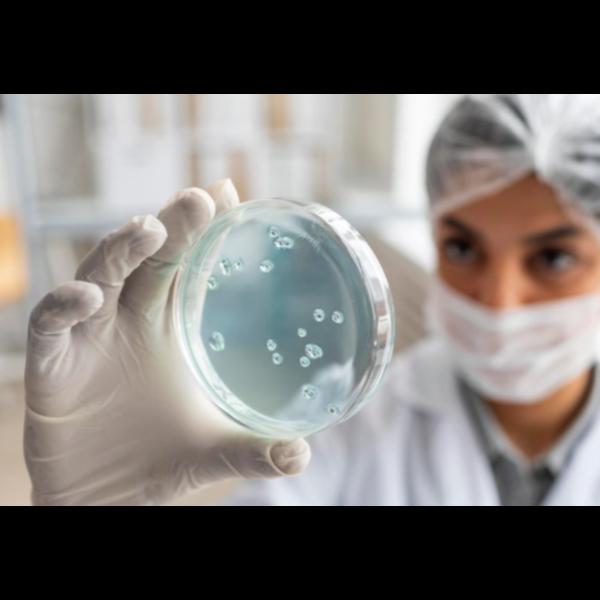

+918042755846
Currently it only shows your basic business info. Start adding relevant business details such as description, images and products or services to gain your customers attention by using Boost 360 android app / iOS App / web portal.

IVF in Mumbai – A Guided Path to Parenthood
View Details
IVF Procedure in Mumbai – Step-by-Step Clarity for Couples
View Details
IVF Procedure in Poonam Nagar, Mumbai for Advanced Fertility Care
View Details
Freezing in Mumbai – Preserving Fertility for the Future
View Details
Fertility Treatment in Poonam Nagar, Mumbai for a Healthy Pregnancy Journey
View Details
IVF Procedure in Mumbai – Science and Sensitivity Combi...
View Details
Egg Donation in Mumbai – A Reliable Solution for A...
View Details
IVF Treatment Cost in Mumbai – A Clear Overview for Couples
View Details